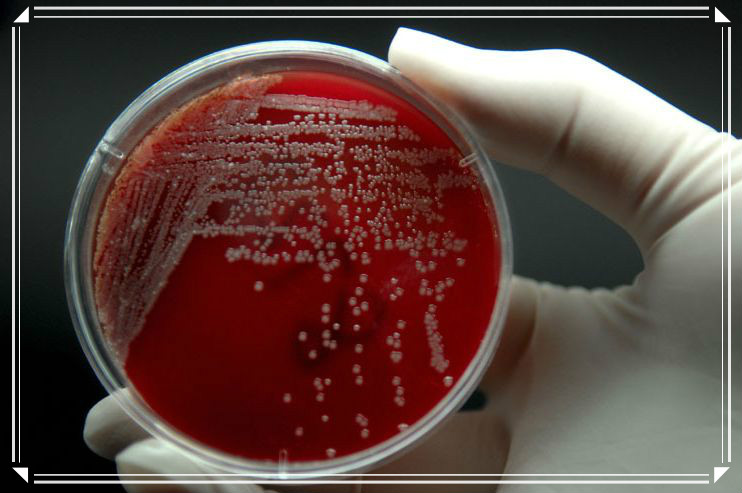

题目
实验七 细菌的鞭毛染色法
实验八 细菌活体运动性的观察 (3学时)
详细内容
目的:学习并掌握细菌鞭毛染色的基本方法,了解细菌鞭毛着生情况。掌握悬滴法和压片法观察细菌运动的基本技术。学会在显微镜下辨别细菌的运动性和非运动性。
重点:鞭毛染色
难点:鞭毛观察
内容:
实验七 细菌的鞭毛染色法
细菌的鞭毛非常纤细,其直径一般为10~20纳米,只有用电子显微镜才能观察到。为了使鞭毛能在光学显微镜下被观察到,就需要用特殊的染色法,该染色法是在染色前用媒染剂处理,使它堆积在鞭毛上,加粗鞭毛的直径,然后再进行染色,以便使鞭毛的直径粗细达到光学显微镜的分辨力限度以内。
实验八 细菌活体运动性的观察
在显微镜下观察细菌的运动性,可初步判断细菌是否有鞭毛。观察时,要适当减弱光强度以增加反差,若光线太强,细菌和周围的液体难以区分。
悬滴法就是将菌液加在洁净的盖玻片中央,在其周围涂上凡士林,然后将它覆盖在凹玻片上,使菌液对准凹槽中央,即可放置在普通光学显微镜下观察。
压片法是将菌液滴在普通的载玻片上,然后盖上盖玻片,置显微镜下观察。
大多数球菌不生鞭毛,杆菌中有的有鞭毛有的无鞭毛,弧菌的螺菌都有鞭毛。有鞭毛的细菌在幼龄时具有较强的运动力,衰老的细胞鞭毛易脱落,故观察时宜选用细龄菌。
指导:
实验七
1.菌种的准备
用新培养的菌种为宜。一般用新制备的斜面(培养基表面湿润,斜面基部有冷凝水)接种后培养10小时。如所用菌种已长期未移种,则最好用新制备的斜面连续移种2~3次(以增强细菌的活动力)后再使用。
注意:良好的培养物,是鞭毛染色成功的基本条件,不宜用已形成芽孢或衰亡期培养物作鞭毛染色的菌种材料,因为老龄细菌鞭毛易脱落。
2.清洗玻片
选择光滑无裂痕的玻片,最好选用新的。为了避免玻片相互重叠,应将玻片插在专用的金属架上,然后将玻片置洗衣粉过滤液(洗衣粉煮沸后用滤纸过滤,以除去粗颗粒)中,煮沸20分钟。取出稍冷后用自来水冲洗、晾干。再放入浓洗液中浸泡5~6天。使用前取出玻片,用自来水冲去残酸,再用蒸馏水洗。将水沥干后,放入95%乙醇中脱水,过火去乙醇,立即使用。
注意:玻片要求光滑、洁净,尤其忌用带油迹的玻片(将水滴在玻片上,无油迹玻片水能均匀散开)。
3.菌液的制备
取斜面或平板菌种培养物数环于盛有1~2 ml无菌水的试管中,制成轻度混浊的菌悬液用于制片。也可用培养物直接制片,但效果不如先制备菌液。
注意:挑菌时尽量不带培养基。
4.制片
取一滴菌液于载玻片的一端,然后将玻片倾斜,使菌液缓缓流向另一端,用吸水纸吸去玻片下端多余的菌液,室温空气中自然干燥。
注意:干后应尽快染色,不宜放置时间过长。
5.染色
涂片干燥后,滴加硝酸银染色A液覆盖3~5分钟,用蒸馏水充分洗去A液。用B液冲去残水后,再加B液覆盖涂片染色约数秒至1分钟,当涂面出现明显褐色时,立即用蒸馏水冲洗。若加B液后显色较慢,可用微火加热,直至显褐色时立即水洗。自然干燥。
注意:配制合格的染色液(尤其是B液),充分洗去A液再加B液,掌握好B液的染色时间均是鞭毛染色成败的重要环节。
6.镜检
干后用油镜观察。观察时可从玻片的一端逐渐移至另一端,有时只在涂片的一定部位观察到鞭毛。
菌体呈深褐色,鞭毛显褐色,通常呈波浪状。
实验报告
绘图表示鞭毛细菌的形态特征。
实验八
一、悬滴法
1.制备菌液
从幼龄菌斜面上,挑取数环菌于盛有1~2 ml无菌水的试管中,制成轻度混浊的菌悬液。
2.涂凡士林
取洁净凹玻片或盖玻片,在其四周涂少许凡士林。
3.滴加菌液
在盖玻片中央滴一小滴菌液。为了便于观察时寻找菌液的位置,可用记号笔在菌液周围画上记号。菌液不能加得太多,为了便于观察,也可用接种环挑取一环菌液于盖玻片中央。
4.盖凹玻片
将凹玻片的凹槽对准盖玻片中心的菌液,并轻轻盖在盖玻片上,轻轻按压使盖玻片与凹玻片粘合在一起,把液滴封闭在小室中。翻转凹玻片,使菌液滴悬在盖玻片下并位于凹槽中央。
注意:若菌液加得过多,此时菌液就会流到凹玻片上面影响观察。
5.镜检
先用低倍镜找到标本,并将液滴移至视野中央,然后用高倍镜观察。若用油镜观察,盖玻片厚度不能超过0.17mm,并要十分小心,以免压碎盖玻片,损坏镜头。
注意:观察过程要在略暗光线下进行。
二、压片法
1.制片
在洁净载玻片上加一滴无菌水,挑取一环菌液与水混合,再加一环0.01%的美蓝水溶液与其混合均匀(这种稀释染料不会把细菌杀死,却会把细菌染上淡淡的颜色,增加细菌与背景的对比,观察起来比较容易)。用镊子取一洁净盖玻片,使其一边与菌液边缘接触,然后将盖玻片慢慢放下盖在菌液上。观察专性好氧菌时,可在放盖玻片时压入小气泡,以防止细菌因缺氧而停止运动。
2.镜检
先用低倍镜找到标本,再用高倍镜观察。也可用油镜观察,用油镜时,盖玻片厚度不能超过0.17mm。观察时,要用略暗光线。
有鞭毛细菌可作直线、波浪式或翻滚运动,两个细菌之间出现明显的移位而与布朗运动或随水流动相区别。
实验报告
记录你所观察到的细菌的运动方式以及运动幅度,并以此判定细菌的鞭毛有无。
4.素材:
实验七
1.菌种:苏云金芽孢杆菌(B.thuringiensis),普通变形杆菌(Proteus vulgaris)斜面菌种(菌龄在15~18小时)
2.染色液:硝酸银鞭毛染色液(A、B液)
A液:丹宁酸5g ,FeCl31.5g ,蒸馏水100ml。待溶解后,加入1%NaOH溶液1ml和15%的甲醛溶液2ml。
B液:硝酸银2g,蒸馏水100ml。
待硝酸银溶解后,取出10ml做回滴用。往90mlB液中滴加浓氢氧化铵溶液,当出现大量沉淀时再继续加氢氧化铵,直到溶液中沉淀刚刚消失变澄清为止。然后用留的10mlB液小心地逐滴加入,至出现轻微和稳定的薄雾为止(此操作非常关键,应格外小心)。在整个滴加过程中要边滴边充分摇荡。配好的染色液当日有效,4小时内效果最好。
3.仪器或其他用品:载玻片,盖玻片,显微镜,接种环,吸水纸,擦镜纸,等。
实验八
1.菌种:金黄色葡萄球菌,青虫杆菌,变通变形杆菌(15~18小时),铜绿假单胞菌(14~18小时)
2.仪器或其他用品:凹玻片,盖玻片,镊子,牙签,接种环,滴管,擦镜纸,凡士林等

